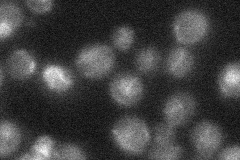
YOL034W
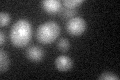
YOL034W
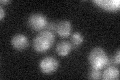
YOL034W

View description
Structural maintenance of chromosomes (SMC) protein; essential subunit of the Mms21-Smc5-Smc6 complex; required for growth and DNA repair; S. pombe homolog forms a heterodimer with S. pombe Rad18p that is involved in DNA repair
Localization:
Intensity:
Fold change:
Significance:
-
C’ GFP library in SD

nucleus18.25 -
N' NOP1pr-GFP in SD

nucleus45.9786 -
N' TEF2pr-mCherry in SD

missing0 -
N' NATIVEpr-GFP in SD
punctate,nucleus16.0519 -
N' TEF2pr-VC and Cyto-VN in SD

#N/A0 -
C’ GFP library in SD+DTT
nucleus16.950.92No -
C’ GFP library in SD+H2O2
nucleus22.851.25No -
C’ GFP library in Starvation Media

nucleus17.030.93No -
C’ GFP library on the background of Pup2-DaMP

nucleus -
C’ GFP library on the background of CCT mutant

nucleus20.4131.11782No
